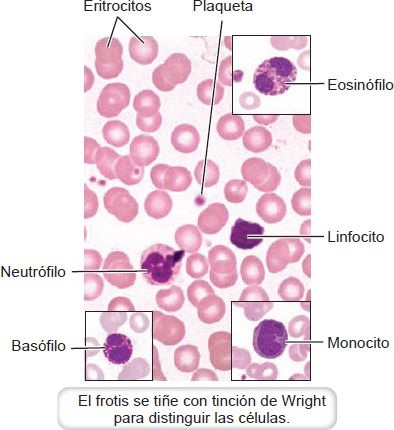
25-2

01. Composición de la sangre y formación de elementos formes
Cuando la sangre es extraída por medios artificiales del cuerpo para hacer una prueba o cuando sale del cuerpo debido a una lesión vascular, se coagula en menos de 30 min a 60 min. El coágulo contiene los componentes celulares de la sangre enredados en fibrina insoluble formada por polimerización del fibrinógeno soluble de la proteína plasmática.
La parte líquida restante de la sangre coagulada es el suero líquido amarillo. Este suero ya no contiene fibrinógeno, porque se consumió en la formación del coágulo. La adición de un anticoagulante (ej. heparina o citrato) a la sangre extraída de la circulación por flebotomía genera un espécimen de sangre entera. Cuando un espécimen de sangre entera se centrifuga, se separa en 3 capas distintas (figura 25-1).

La capa del fondo (aproximadamente del 42% al 47% del volumen de sangre entera) contiene eritrocitos o glóbulos rojos (GR). El hematocrito, una prueba sanguínea, es la relación entre este volumen de GR empaquetados en la capa del fondo y el volumen total de sangre dentro del tubo de ensayo. La capa intermedia de apariencia esponjosa (alrededor del 1%) que contiene los leucocitos o glóbulos blancos es blanca o gris y se denomina capa leucocítica. Arriba de los leucocitos está una capa delgada de trombocitos o plaquetas que no es discernible a simple vista.
El líquido translúcido amarillento que se forma en la parte superior de las células es el plasma, el cual comprende alrededor del 55% del volumen total. La principal diferencia entre plasma y suero es la presencia de fibrinógeno en el plasma de una muestra de sangre entera centrifugada y anticoagulada. El suero no contiene fibrinógeno porque el que estaba presente en la sangre sin coagular se utilizó en la formación del coágulo.
Plasma
El plasma, un líquido, está constituido por del 90% al 91% de agua por peso, del 6,5% al 8% de proteínas por peso y el 2% de otras pequeñas sustancias moleculares (tabla 25-1). El agua del plasma funciona como un vehículo para los materiales que se transportan en la sangre. Como medio de transporte, el plasma lleva nutrientes desde el tubo digestivo y oxígeno desde los pulmones a las células del cuerpo al tiempo que recoge los desechos celulares para entregarlos a los órganos que se encargan de la excreción. También transporta hormonas y facilita el intercambio de mediadores químicos. El plasma participa en el equilibrio electrolítico y en el acidobásico, y contiene las proteínas plasmáticas que contribuyen a la regulación osmótica de los líquidos corporales. Además, ya que el agua posee una gran capacidad para conservar el calor, el plasma absorbe y distribuye gran parte del calor que se genera en el cuerpo.
| Plasma | Porcentaje de volumen del plasma | Descripción |
|---|---|---|
| Agua | 90-91 | |
| Proteínas: albúmina globulinas fibrinógeno | 6,8-8 | 54% de las proteínas del Plasma 38% de las proteínas del Plasma 7% de las proteínas del plasma |
| Otras sustancias | 1-2 | Hormonas, enzimas, carbohidratos, grasa, aminoácidos, gases, electrolitos, productos de excreción |
Proteínas del plasma
Son los solutos más abundantes del plasma. La presencia de estas proteínas es lo que distingue la composición del plasma de la del líquido intersticial. Los principales tipos de proteínas plasmáticas son albúmina, globulinas y fibrinógeno. Excepto por las hormonas transportadas por la sangre y las γ-globulinas, la mayor parte de las proteínas plasmáticas se produce en el hígado, que las secreta hacia la sangre.
La albúmina es la más abundante y constituye un total aproximado del 54% de las proteínas plasmáticas. No atraviesa los poros de la pared capilar para entrar al líquido intersticial y, por lo tanto, contribuye a la presión osmótica del plasma y al mantenimiento del volumen sanguíneo. La albúmina también funciona como un transportador de ciertas sustancias y actúa como una solución amortiguadora de la sangre.
Las globulinas comprenden cerca del 38% de las proteínas plasmáticas. Hay 3 tipos de globulinas: las α-globulinas, que transportan bilirrubina y esteroides; las β-globulinas, que transportan hierro y cobre; y las γ-globulinas, que son los anticuerpos del sistema inmunitario.
El fibrinógeno constituye alrededor del 7% de las proteínas plasmáticas. Es una proteína soluble que se polimeriza para formar la proteína insoluble fibrina durante la coagulación de la sangre. El 1% restante de las proteínas circulantes está formado por hormonas, enzimas, complemento y transportadores de los lípidos.
Elementos formes de la sangre
Incluyen eritrocitos, leucocitos y plaquetas, que se originan en la médula ósea. En la figura 25-2 se ilustra un frotis de sangre. No todas las células de la sangre, o elementos formes, son células verdaderas. Los eritrocitos carecen de núcleo u orgánulos, y las plaquetas sólo son fragmentos celulares. La mayor parte de los elementos formes no se divide. Por lo tanto, la división celular en la médula ósea tiene que renovarlas continuamente.
Eritrocitos
Los eritrocitos, o glóbulos rojos (GR), son los más numerosos de los elementos formes. Son pequeños discos bicóncavos con un diametro promedio de 7,8 μm y un espesor cercano a 2,5 μm.
El volumen medio de un GR promedio es de aproximadamente 90 μm. Los GR poseen un área superficial enorme y se deforman con facilidad tomando casi cualquier configuración para pasar por los pequeños vasos capilares del sistema circulatorio. Contienen la proteína transportadora de oxigeno, hemoglobina, cuya función es transportar oxigeno. Los GR puede concentrar hemoglobina en el liquido celular hasta aproximadamente 34 gramos por cada 100 ml de células.
El 90% de los eritrocitos, cuyo origen es la médula ósea, vive alrededor de 120 días en la circulación y luego son fagocitados en la médula ósea, el bazo y el hígado. El otro 10% de GR se descompone y excreta pequeñas cantidades de hemoglobina hacia el sistema circulatorio. Los precursores de los eritrocitos en la médula ósea poseen núcleos, pero no sólo expelen sus núcleos, sino también todos los orgánulos antes de entrar a la circulación.
Aunque los eritrocitos carecen de orgánulos, tienen enzimas solubles, incluida anhidrasa carbónica, dentro de su citosol. Esta enzima facilita la formación de ácido carbónico a partir de dióxido de carbono y agua, que a su vez se disocia en bicarbonato e iones de hidrógeno. Por consiguiente, los eritrocitos también contribuyen al transporte de dióxido de carbono y la regulación del equilibrio acidobásico, y se les considera un amortiguador acidobásico superior.
Leucocitos
También conocidos como glóbulos blancos, miden de 10 μm a 12 μm de diámetro y por consiguiente son mucho más grandes que los GR. No obstante, constituyen sólo el 1% del volumen total de la sangre. Se originan en la médula ósea y circulan por todos los tejidos linfoides del organismo. Los leucocitos son factores clave en la defensa contra las enfermedades de las siguientes maneras:
- Se encargan de la respuesta inmunitaria que protege contra los microorganismos que causan enfermedades.
- Identifican y destruyen células cancerosas.
- Participan en la respuesta inflamatoria y la curación de heridas.
Por lo general, los leucocitos se clasifican en 2 grupos con base en la presencia o ausencia de gránulos específicos prominentes en su citoplasma (figura 25-3). Los que contienen gránulosespecíficos (neutrófilos, eosinófilos, basófilos) se clasifican como granulocitos y los que carecen de gránulos (linfocitos y monocitos), como agranulocitos.

Granulocitos
Son esféricos y tienen núcleos multilobulares distintivos. Son células fagocíticas que se identifican por sus gránulos citoplásmicos. Poseen 2 tipos de gránulos: gránulos específicos que enlazan componentes de tinción neutros, básicos o ácidos, y gránulos azurófilos. Los gránulos azurófilos se tiñen de color púrpura y son lisosomas. Los granulocitos se dividen en 3 tipos: neutrófilos, eosinófilos y basófilos, según las propiedades de tinción de sus gránulos específicos.
Neutrófilos
Constituyen del 55% al 65% del total de leucocitos; poseen gránulos que son neutros y, por tanto, no se tiñen con tinción ácida o básica. Puesto que estas células tienen núcleos que están divididos en 3 a 5 lóbulos, a menudo se denominan polimorfos o leucocitos polimorfonucleares o PMN.
Los neutrófilos se ocupan principalmente de mantener normales las defensas del huésped contra bacterias y hongos invasores, desechos celulares y una variedad de sustancias extrañas. El citoplasma de los neutrófilos maduros tiene 3 tipos de gránulos:
- Gránulos específicos pequeños que contienen activadores del complemento y agentes bacteriostáticos y bactericidas.
- Gránulos más grandes azurófilos que contienen peroxidasas y otras enzimas hidrolíticas.
- Gránulos terciarios recién descubiertos, los cuales contienen proteínas que, según se cree, facilitan el movimiento y la migración del neutrófilo.
Los neutrófilos son muy móviles y son las primeras células en ir hacia una zona con daño tisular. Su migración es resultado de la liberación de moléculas de adhesión sobre la superficie del neutrófilo, la cual se conecta con ligandos sobre las células endoteliales. Los neutrófilos tienen su origen en los mieloblastos que se encuentran en la médula ósea (figura 25-4).

Los mieloblastos son los precursores comprometidos de la vía de los granulocitos y en condiciones normales no aparecen en la circulación periférica. Su presencia sugiere un trastorno en la proliferación y diferenciación de los elementos formes. Los mieloblastos se diferencian en promielocitos y luego en mielocitos. Una célula no suele llamarse mielocito hasta que tiene por lo menos 12 gránulos. Los mielocitos maduran y se transforman en metamielocitos, momento en el que pierden su capacidad para la mitosis.
El desarrollo posterior del neutrófilo comprende reducción de tamaño, con transformación del núcleo desde un óvalo hasta uno en forma de herradura (es decir, células en banda) y luego en una célula madura con núcleo segmentado. A menudo los neutrófilos maduros se denominan segs por su núcleo segmentado. El desarrollo desde célula madre a neutrófilo maduro tarda alrededor de 2 semanas. Es el momento en que el neutrófilo entra al torrente sanguíneo.
Neutrofilia es un incremento de neutrófilos inmaduros (en forma de «banda») que se observa en la sangre periférica. Lo más común es verlos en las infecciones agudas y lesiones de tejidos que favorecen la liberación acelerada de neutrófilos y sus precursores a la circulación.
Una vez que los neutrófilos son liberados desde la médula ósea, pasan alrededor de 4 h a 8 h en la circulación antes de desplazarse hacia los tejidos. Sobreviven en los tejidos aproximadamente de 4 a 5 días. Mueren en los tejidos al cumplir su función fagocítica o por senescencia. El total de neutrófilos circulantes (es decir, los que aparecen en el hemograma) está en un equilibrio estrechamente mantenido con un total similar de células que se acomodan a lo largo de las paredes de los vasos sanguíneos pequeños. Éstos son los neutrófilos que responden a factores quimiotácticos y migran a los tejidos hacia el agente problemático.
Adrenalina, ejercicio, estrés y tratamiento farmacológico con corticosteroides pueden hacer que la cuenta de neutrófilos circulantes aumente con rapidez porque se desplazan las células que están en las orillas y se mezclan al total que está en la circulación. Las endotoxinas o microorganismos tienen el efecto contrario al producir un decremento momentáneo de neutrófilos por la atracción de éstos hacia los tejidos.
Eosinófilos
Son similares en cuanto a dimensiones a los neutrófilos. Los gránulos citoplásmicos específicos de los eosinófilos se tiñen de rojo con eosina ácida. Estos leucocitos constituyen del 1% al 3% del total de glóbulos blancos y aumentan en número durante reacciones alérgicas e infecciones parasitarias. En las reacciones alérgicas, se supone que liberan enzimas o mediadores químicos que destoxifican los agentes vinculados con las reacciones alérgicas.
Los eosinófilos liberan arilsulfatasa e histaminasas en lugares de reacciones alérgicas y se cree que esto disminuye el potencial efecto negativo de los mediadores que se liberan con la inflamación. En las infecciones parasitarias loseosinófilos usan marcadores de superficie para adherirse al parásito y luego liberar enzimas hidrolíticas que lo matan. Por lo tanto, las personas con reacciones alérgicas o parásitos helmínticos tendrán un incremento de eosinófilos en el hemograma completo. Los individuos con enfermedades gastrointestinales eosinofílicas tienen una concentración de eosinófilos copiosa en la mucosa del tubo digestivo, lo que causa enfermedad según se ha determinado. Sin embargo, aún no se identifica ningún proceso inmunorregulador etiológico específico.
Basófilos
También de dimensiones similares a las de los neutrófilos, son los menos numerosos de los glóbulos blancos: constituyen sólo del 0,3% al 0,5% del total de leucocitos. Los gránulos específicos de los basófilos se tiñen de azul con tinción básica. Estos gránulos contienen heparina, un anticoagulante; histamina, un vasodilatador; y otros mediadores de inflamación, como leucotrieno que causa broncoconstricción de los músculos lisos de las vías respiratorias pulmonares.
Los basófilos, que son elementos formes de la sangre, están relacionados con las células cebadas del tejido conectivo que contienen gránulos similares pero no son idénticas a ellas. Se supone que tanto los basófilos como las células ceba-das participan en las reacciones alérgicas y de hipersensibilidad.
Linfocitos
Son los agranulocitos más comunes y conforman del 20% al 30% del total de los leucocitos. Se originan en la médula ósea a partir de células madre linfoides y son las principales células funcionales del sistema inmunitario. Se desplazan entre la sangre y el tejido linfático, donde pueden almacenarse por horas o años. Su función en los ganglios linfáticos o el bazo es defender contra los microorganismos mediante la respuesta inmunitaria.
Hay 3 tipos de linfocitos: linfocitos B12, linfocitos T y células citotóxicas naturales.
Los linfocitos B (células B) se llaman así porque se identificaron primero como una población separada en la bolsa de Fabricio en aves y órganos con una bolsa similar (ej. médula ósea) en mamíferos. Se diferencian para formar células plasmáticas productoras de anticuerpos y participan en la inmunidad humoral.
Los linfocitos T (células T) se diferencian en el timo. Activan otras células del sistema inmunitario (células T cooperadoras) y se relacionan con la inmunidad mediada por células (células T citotóxicas).
Las células citotóxicas naturales participan en la inmunidad innata o natural, y su función es destruir las células extrañas.
Los linfocitos de los 3 subconjuntos poseen marcadores de superficie exclusivos que pueden identificarse y ayudan a definir sus funciones y a diagnosticar enfermedades. El fallo de linfocitos incluye un 80% de células T, un 10% de células B y un 10% de células citotóxicas. Los principales antígenos de histocompatibilidad, también conocidos como antígenos leucocitaros humanos (ALH), se expresan en los linfocitos y determinan varios aspectos de la respuesta inmunitaria humana.
Monocitos y macrófagos
Los monocitos son los más grandes de los leucocitos y constituyen entre el 3% y el 8% del total de éstos. Se distinguen por una enorme cantidad de citoplasma y un núcleo oscuro en forma de riñón. El lapso que los monocitos se encuentran en la circulación es de alrededor de 1 a 3 días, 3 o 4 veces más que el de los granulocitos. Estas células sobreviven durante meses o años en los tejidos.
Los monocitos, que son los precursores del sistema fagocítico mononuclear, a menudo se denominan macrófagos cuando entran a los tejidos. Los monocitos engullen cantidades más grandes de material extraño y de mayor tamaño que los neutrófilos. Estos leucocitos desempeñan una función importante en la inflamación crónica y también se relacionan con la respuesta inmunitaria porque activan los linfocitos y presentan antígenos a las células T. Cuando el linfocito abandona el sistema vascular y entra a los tejidos, actúa como macrófago con actividad específica.
Los macrófagos se conocen como histiocitos en el tejido conectivo liso, células de microglia en el cerebro y células de Kupffer en el hígado. Otros macrófagos actúan en los alvéolos, ganglios linfáticos y otros tejidos.
La inflamación granulomatosa es un patrón distintivo de inflamación crónica en el que los macrófagos forman una cápsula alrededor del material insoluble que no puede digerirse. Cuerpos extraños relativamente inertes, como talco o suturas quirúrgicas, propician la formación de granulomas de cuerpo extraño. Los granulomas inmunes son causados por partículas insolubles capaces de incitar una respuesta inmunitaria mediada por células. El tubérculo que se forma en las infecciones tuberculosas primarias es un ejemplo de este tipo de granulomas.
Trombocitos
Los trombocitos, o plaquetas, son fragmentos celulares circulantes de megacariocitos enormes que se derivan de la célula madre mieloide. Su función es formar un tapón de plaquetas para ayudar a controlar la hemorragia después de una lesión en la pared de un vaso (figura 25-5). Sus gránulos citoplásmicos liberan mediadores que la sangre necesita en su proceso de coagulación.
Los trombocitos tienen una membrana, pero no núcleo, no se reproducen y, si no se utilizan, duran alrededor de 10 días en la circulación antes que las células fagocíticas del bazo los eliminen.

Formación de elementos formes (hematopoyesis)
La generación de los elementos formes tiene lugar en el sistema hematopoyético (del griego haima, «sangre», y poiesis, «hacer»).
El sistema hematopoyético comprende todos los elementos formes y sus precursores, la médula ósea donde se originan y los tejidos linfoides donde algunos elementos formes circulan conforme se desarrollan y maduran.
La hematopoyesis inicia en las células endoteliales de los vasos sanguíneos en desarrollo durante la quinta semana de gestación y continúa en el hígado y el bazo. Después del nacimiento, la médula ósea asume gradualmente esta función. Una parte de la hematopoyesis también puede ocurrir en el bazo o el hígado. La médula ósea es una red de tejido conectivo que contiene elementos formes inmaduros. En los lugares donde la médula es hematopoyéticamente activa, produce tantos eritrocitos que es de color rojo, de ahí el nombre de médula ósea roja. También están presentes células de grasa en la médula ósea, pero son inactivas por lo que se refiere a generación de elementos formes. La célula grasa puede verse en la médula ósea de la figura 25-6.

La médula que está formada sobre todo por células grasas se llama médula ósea amarilla. Durante el crecimiento esquelético activo, la médula roja es reemplazada de manera gradual por médula amarilla en la mayor parte de los huesos largos. En los adultos, la médula roja está restringida en gran medida a los huesos planos de la pelvis, las costillas y el esternón. Cuando la demanda de reemplazo de células rojas aumenta, como en la anemia hemolítica, la médula roja puede resustituirse por médula amarilla.
Precursores de los elementos formes
La población de elementos formes de la sangre de la médula ósea está conformada por 3 tipos de células: células madre autorrenovables, células progenitoras (parentales) diferenciadas y elementos formes funcionales maduros.
Todos los precursores de los elementos formes de las series de eritrocitos (es decir, glóbulos rojos), mielocitos (es decir, granulocito o monocito), linfocitos (es decir, linfocito T y linfocito B) y megacariocitos (es decir, plaquetas) se derivan de una pequeña población de células primitivas llamadas células madre pluripotenciales (figura 25-7). El potencial que poseen en toda su vida para proliferar y autorrenovarse las hace una fuente indispensable y salvadora de las células de reserva para todo el sistema hematopoyético.

Varios niveles de diferenciación conducen al desarrollo de células unipotenciales comprometidas, que son las progenitoras de cada uno de los tipos de elementos formes. Estas células se conocen como unidades formadoras de colonias (UFC). Estas células progenitoras tienen sólo capacidad limitada para la autorrenovación pero conservan el potencial para diferenciarse en células precursoras de un linaje específico.
Las células precursoras poseen características morfológicas que las identifican como las primeras células de una línea celular particular. Han perdido su capacidad para autorrenovarse pero experimentan división celular y diferenciación, y con el tiempo originan linfocitos, mielocitos, megacariocitos o eritrocitos maduros.
Regulación de la hematopoyesis
En condiciones normales, la cantidad y masa total de cada tipo de elemento forme circulante permanecen relativamente constantes. Los elementos formes se producen en cantidades distintas según las necesidades y los factores reguladores. Se supone que esta regulación de los elementos formes está por lo menos parcialmente controlada por factores de crecimiento similares a las hormonas, llamados citocinas.
Las citocinas son una familia de mediadores de vida corta que estimulan la proliferación, diferenciación y activación funcional de los distintos elementos formes.
Muchas citocinas que se derivan de linfocitos o de células de estroma de médula ósea estimulan el crecimiento y la producción de nuevos elementos formes. Algunos miembros de esta familia se llaman factores estimuladores de colonias (FEC) por su habilidad para promover el crecimiento de colonias de células hematopoyéticas en el laboratorio.
Los FEC que actúan sobre las células progenitoras comprometidas incluyen:
- eritropoyetina (EPO), que estimula la producción de GR;
- factor estimulante de colonias de granulocitos-monocitos (FEC-GM), el cual estimula los progenitores de granulocitos, monocitos, eritrocitos y megacariocitos;
- factor estimulante de colonias de granulocitos (FEC-G), el cual promueve la proliferación de neutrófilos;
- factor estimulante de colonias de macrófagos (FEC-M), que induce las colonias de macrófagos; y
- trombopoyetina (TPO), la cual estimula la diferenciación de las plaquetas.
Otras citocinas, como interleucinas, interferones y factor de necrosis tumoral, apoyan la proliferación de células madre y el desarrollo de linfocitos, y actúan de forma sinérgica para ayudar en las diversas funciones de los FEC.
Los genes de la mayor parte de los factores de crecimiento hematopoyético se han clonado y han generado sus proteínas recombinantes para emplearlas en una gran variedad de problemas clínicos.
Algunos ejemplos de factores con utilidad clínica son EPO, TPO, FEC-G y FEC-GM. Se emplean para tratar la insuficiencia de médula ósea causada por quimioterapia o anemia aplásica, anemia de la insuficiencia renal y cáncer, neoplasias hematopoyéticas, enfermedades infecciosas como elsíndrome de inmunodeficiencia adquirida (sida) y enfermedades congénitas y mieloproliferativas.
Los factores de crecimiento se utilizan para aumentar las células madre periféricas para trasplante y para acelerar la proliferación celular después de trasplante de médula ósea. Muchas de estas formas de utilización todavía se investigan y se crean nuevos factores.
Trastornos de las células madre hematopoyéticas
Es posible que la poca proliferación de la población de células madre ocasione un fallo en la producción de uno o varios tipos de células. Por ejemplo, se desarrolla anemia aplásica cuando las células madre multipotencial dejan de crecer y de proveer células para la diferenciación. El resultado es anemia, trombocitopenia y granulocitopenia (pancitopenia) concurrentes. Por otro lado, las enfermedades mieloproliferativas se caracterizan por una médula ósea hipercelular y una tendencia a elevadas cantidades de sangre periférica. La producción excesiva no regulada de la masa de eritrocitos se denomina policitemia. Hay trombocitosis cuando la médula ósea produce demasiadas plaquetas. Las leucemias representan una diversidad de enfermedades que se caracterizan por una proliferación anómala de leucocitos.
En la curación potencial de ésta y muchas otras afecciones se utilizan células madre hematopoyéticas como parte del tratamiento. Muchas personas con leucemia reciben trasplantes de células madre que ayudan de modo notable a lograr una remisión. Los trasplantes de células madre se centran en corregir la insuficiencia de la médula ósea, inmunodeficiencias, defectos y tumores hematológicos, así como errores del metabolismo heredados. Las fuentes de células madre incluyen la médula ósea y la sangre del cordón umbilical, los cuales rellenan el recipiente con una población normal de células madre pluripotenciales. Los trasplantes de células madre pueden provenir del mismo paciente (autólogo) o de un donador histocompatible (alógeno). A menudo, se recurre a los trasplantes autólogos para reponer las células madre después de una dosis alta de quimioterapia o radiación. La sangre del cordón umbilical procedente de donadores de ALH compatibles es una opción de trasplante para niños y tiene menos riesgo de enfermedad injerto contra huésped. En los capítulos 26, 27 y 28 se describen con más detalle la patogénesis, las manifestaciones clínicas y el tratamiento de estos trastornos de células madre.